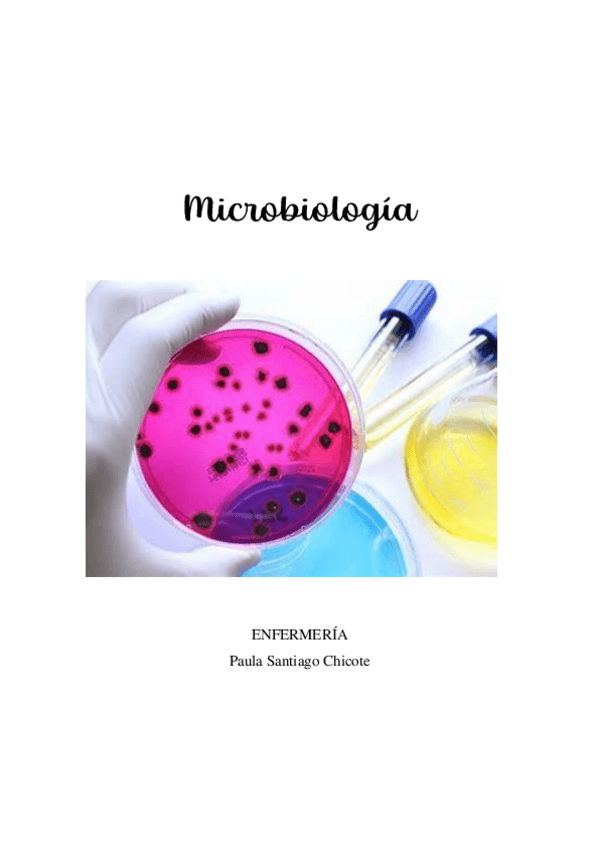

@Pascenf
36 Publicaciones
1.54k Interacciones
0 Seguidores
4 Siguiendo
Lista de publicaciones de Pascenf
apuntes
-
Apuntes vejez
He publicado nuevos apuntes de 2º Enfermería en la vejez y atención a la dependencia: Apuntes vejez
apuntes
-
Aparato digestivo
He publicado nuevos apuntes de 2º Enfermería en alteraciones de la salud II: Aparato digestivo
He publicado nuevos apuntes de 2º Inglés Técnico: VOCABULARIO-INGLES-PRIMER-CUATRIMESTRE-2.pdf
He publicado nuevos apuntes de 1º Biología: APUNTES-MICROBIOLOGIA.pdf
He publicado nuevos apuntes de 1º Biología: Apuntes-microbiologia-introduccion-y-bacterias..pdf
He publicado nuevos examenes de 2º Enfermería en alteraciones de la salud I: EXAMEN-alteraciones.pdf
He publicado nuevos examenes de 2º Enfermería en alteraciones de la salud I: EXAMEN-ALTERACIONES.pdf
He publicado nuevos apuntes de 1º Biología: Esquemas microbiología.pdf
He publicado nuevos examenes de 2º Enfermería en la infancia y adolescencia: Test-Infancia-resuelto-GRUPOS-1-Y-2.pdf
He publicado nuevos examenes de 2º Enfermería en la vejez y atención a la dependencia: Vejez-2020.pdf
He publicado nuevos examenes de 2º Enfermería en alteraciones de la salud II: EXAMENES-ALTERACIONES-II-sin-respuestas.pdf
He publicado nuevos examenes de 2º Enfermería en alteraciones de la salud II: examen-Alteraciones-2019-2020.pdf
He publicado nuevos apuntes de 2º Enfermería en alteraciones de la salud I: infecciones-nosocomiales-y-EPINE.pdf
He publicado nuevos apuntes de 2º Enfermería en alteraciones de la salud I: Tema-2-Electrocardiografia.pdf
He publicado nuevos examenes de 1º Estadística, sistemas de información y nuevas tecnologías: PREGUNTAS-RESUELTAS-EXAMEN-ESTADISTICA.pdf
He publicado nuevos examenes de 1º Bioquímica y Biofísica: EXAMEN-BIOQUIMICA-1.pdf
He publicado nuevos examenes de 1º Fundamentos metodológicos de la enfermería: EXAMEN-FUNDAMENTOS-METODOLOGICOS-2020.pdf
He publicado nuevos apuntes de 1º Estructura y Función del Cuerpo Humano I: EXAMEN-ESTRUCTURA.pdf
He publicado nuevos examenes de 1º Salud Pública: EXAMEN-SALUD-2015-2016.pdf
He publicado nuevos examenes de 1º Fundamentos históricos y teóricos de la Enfermería: EXAMEN-TEST-FUNDAMENTOS.pdf